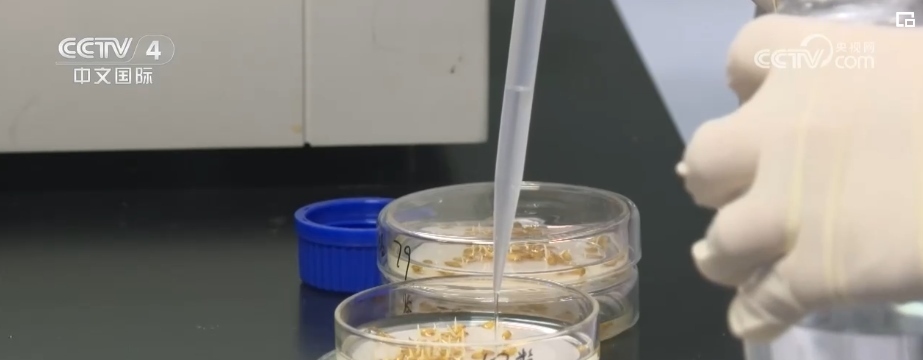

央視網(wǎng)消息:12月19日至20日在北京召開(kāi)的中央農(nóng)村工作會(huì)議,分析當(dāng)前“三農(nóng)”工作面臨的形勢(shì)和挑戰(zhàn),部署2024年“三農(nóng)”工作。提出堅(jiān)持農(nóng)業(yè)農(nóng)村優(yōu)先發(fā)展,精準(zhǔn)務(wù)實(shí)培育鄉(xiāng)村產(chǎn)業(yè),實(shí)施農(nóng)民增收促進(jìn)行動(dòng),以加快農(nóng)業(yè)農(nóng)村現(xiàn)代化更好推進(jìn)中國(guó)式現(xiàn)代化建設(shè)。
確保明年糧食產(chǎn)量保持在1.3萬(wàn)億斤以上

保障糧食和重要農(nóng)產(chǎn)品穩(wěn)定安全供給,始終是建設(shè)農(nóng)業(yè)強(qiáng)國(guó)的頭等大事。中央農(nóng)村工作會(huì)議強(qiáng)調(diào),要抓好糧食和重要農(nóng)產(chǎn)品生產(chǎn),穩(wěn)定糧食播種面積,推動(dòng)大面積提高糧食單產(chǎn),鞏固大豆擴(kuò)種成果,確保2024年糧食產(chǎn)量保持在1.3萬(wàn)億斤以上。
農(nóng)業(yè)農(nóng)村部:聚焦糧油大面積單產(chǎn)提升

農(nóng)業(yè)農(nóng)村部表示,2024年糧油播種面積要保持總體穩(wěn)定,有條件的地方挖潛擴(kuò)面,產(chǎn)量上穩(wěn)中求進(jìn),在優(yōu)化品種品質(zhì)的前提下力爭(zhēng)多增。
確保耕地質(zhì)量數(shù)量 建設(shè)高標(biāo)準(zhǔn)農(nóng)田

保障糧食安全、提高糧食產(chǎn)能,首先要確保耕地質(zhì)量和數(shù)量。會(huì)議提出,健全耕地?cái)?shù)量、質(zhì)量、生態(tài)“三位一體”保護(hù)制度體系。優(yōu)先把東北黑土地區(qū)、平原地區(qū)、具備水利灌溉條件地區(qū)的耕地建成高標(biāo)準(zhǔn)農(nóng)田,適當(dāng)提高投資補(bǔ)助水平。
探索建立產(chǎn)銷區(qū)省際橫向利益補(bǔ)償機(jī)制

同時(shí),探索建立糧食產(chǎn)銷區(qū)省際橫向利益補(bǔ)償機(jī)制。專家表示,這一舉措有利于主產(chǎn)區(qū)做大做強(qiáng)糧食產(chǎn)業(yè),縮小地區(qū)間發(fā)展差異,更好保障糧食安全。
支持科技創(chuàng)新平臺(tái)建設(shè) 推進(jìn)種業(yè)振興

會(huì)議還圍繞強(qiáng)化科技和改革雙輪驅(qū)動(dòng)作出系列重要部署,明確支持農(nóng)業(yè)科技創(chuàng)新平臺(tái)建設(shè)、加快推進(jìn)種業(yè)振興行動(dòng)。近年來(lái),中國(guó)農(nóng)業(yè)關(guān)鍵技術(shù)和重大品種陸續(xù)取得突破,農(nóng)業(yè)科技進(jìn)步貢獻(xiàn)率達(dá)到62.4%。
培育鄉(xiāng)村產(chǎn)業(yè) 實(shí)施農(nóng)民增收促進(jìn)行動(dòng)



會(huì)議提出,精準(zhǔn)務(wù)實(shí)培育鄉(xiāng)村產(chǎn)業(yè),完善聯(lián)農(nóng)帶農(nóng)機(jī)制,實(shí)施農(nóng)民增收促進(jìn)行動(dòng),讓廣大農(nóng)民真切嘗到鄉(xiāng)村產(chǎn)業(yè)發(fā)展“甜頭”。
北疆新聞:內(nèi)蒙古自治區(qū)重點(diǎn)新聞網(wǎng)站(客戶端),內(nèi)蒙古出版集團(tuán)新華報(bào)業(yè)中心旗下國(guó)家互聯(lián)網(wǎng)新聞信息采編發(fā)布服務(wù)一類資質(zhì)網(wǎng)站(客戶端)。
北疆新聞版權(quán)與免責(zé)聲明:
一、凡本站中注明“來(lái)源:北疆新聞”的所有文字、圖片和音視頻,版權(quán)均屬北疆新聞所有,轉(zhuǎn)載時(shí)必須注明“來(lái)源:北疆新聞”,并附上原文鏈接。
二、凡來(lái)源非北疆新聞的新聞(作品)只代表本網(wǎng)傳播該消息,并不代表贊同其觀點(diǎn)。
如因作品內(nèi)容、版權(quán)和其它問(wèn)題需要同本網(wǎng)聯(lián)系的,請(qǐng)?jiān)谝?jiàn)網(wǎng)后30日內(nèi)進(jìn)行,聯(lián)系郵箱:bjwmaster@163.com。
版權(quán)聲明:北疆新聞版權(quán)所有,未經(jīng)書(shū)面授權(quán),不得轉(zhuǎn)載或建立鏡像,違者依法必究。 本站違法和不良信息舉報(bào)電話:15648148811蒙ICP備16001043號(hào)-1
Copyright © 2016- 北疆新聞網(wǎng) All Rights Reserved互聯(lián)網(wǎng)新聞信息服務(wù)許可證:15120200009-1蒙公網(wǎng)安備:15010502001245